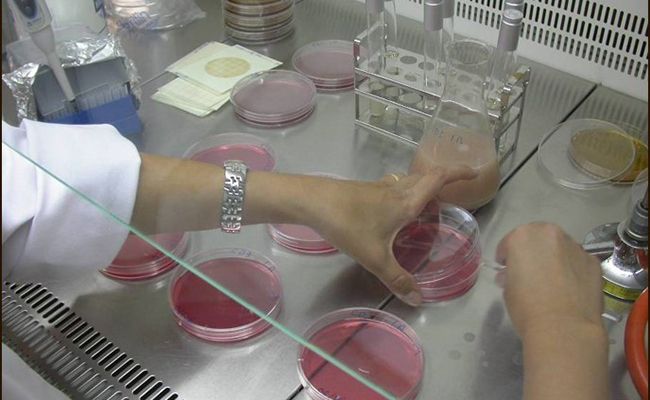

SEGURIDAD ALIMENTARIA
La Junta busca incrementar la seguridad alimentaria con sensores en el proceso de producción de derivados cárnicos
El proyecto de investigación ‘Iberic-Sensotracing’, liderado por Itacyl, estudia nuevas técnicas para el control efectivo de patógenos alimentarios en los productos de cerdo ibérico que permitan a los operadores ofrecer al consumidor productos todavía más seguros
La Junta de Castilla y León promueve la implantación de sensores en el proceso de producción de derivados cárnicos que permitan la monitorización en tiempo real de las diferentes fases del mismo y, de este modo, incrementar la seguridad alimentaria.
Este es el objetivo de un proyecto de investigación denominado ‘Iberic-Sensotracing’ que, liderado por Itacyl, estudia nuevas técnicas que faciliten las labores de vigilancia y control efectivo de patógenos alimentarios en la elaboración de productos de cerdo ibérico, permitiendo a los operadores ofrecer al consumidor alimentos todavía más seguros y, en consecuencia, favorecer un mayor desarrollo comercial del sector.
Para llevar a cabo este proyecto, financiado con fondos FEADER y coordinado por el equipo de la Estación Tecnológica de la Carne de Itacyl ubicado en Guijuelo, se cuenta con la colaboración de varias industrias cárnicas de la Comunidad, en las que se implantarán distintos sistemas para el control de ambientes de las zonas de producción. En concreto, se persigue el control efectivo de microorganismos patógenos como la ‘Listeria monocytogenes’, con capacidad para crecer sobre superficies, equipos y entornos alimentarios.
En este sentido, se han desarrollado sistemas de monitoreo, como sensores de control de higiene, capaces de simular de forma efectiva las condiciones del entorno de procesado de alimentos y que representan una alternativa simple y eficiente a los métodos convencionales utilizados para el muestreo de superficies.
De forma adicional, se ha implantado un sistema de identificación y seguimiento mediante técnicas de análisis genético que permiten discriminar con precisión entre diferentes cepas de ‘listeria’ a lo largo de la cadena de producción de alimentos. De este modo se determina cuáles son las cepas predominantes y, por tanto, cuáles son las más resistentes a desinfectantes o a condiciones ambientales, aspectos clave para las industrias del sector.
Sector cárnico
La industria cárnica española es el ámbito de mayor importancia dentro de la industria de alimentación y bebidas. Castilla y León cuenta con más de 800 industrias, que suponen algo más del 26 % del total de las empresas agroalimentarias, con una producción del 12,5 % del volumen de carne en España. La calidad de los productos castellanos y leoneses se ve reflejada tanto en el número de figuras de reconocimiento (23) como en el incremento del volumen de exportaciones que se ha experimentado en los últimos años. Para los productores, garantizar la seguridad alimentaria es primordial, por lo que el control de microorganismos como puede ser la ‘Listeria monocytogenes’ constituye una prioridad.
La Junta de Castilla y León promueve la implantación de sensores en el proceso de producción de derivados cárnicos que permitan la monitorización en tiempo real de las diferentes fases del mismo y, de este modo, incrementar la seguridad alimentaria.
Este es el objetivo de un proyecto de investigación denominado ‘Iberic-Sensotracing’ que, liderado por Itacyl, estudia nuevas técnicas que faciliten las labores de vigilancia y control efectivo de patógenos alimentarios en la elaboración de productos de cerdo ibérico, permitiendo a los operadores ofrecer al consumidor alimentos todavía más seguros y, en consecuencia, favorecer un mayor desarrollo comercial del sector.
Para llevar a cabo este proyecto, financiado con fondos FEADER y coordinado por el equipo de la Estación Tecnológica de la Carne de Itacyl ubicado en Guijuelo, se cuenta con la colaboración de varias industrias cárnicas de la Comunidad, en las que se implantarán distintos sistemas para el control de ambientes de las zonas de producción. En concreto, se persigue el control efectivo de microorganismos patógenos como la ‘Listeria monocytogenes’, con capacidad para crecer sobre superficies, equipos y entornos alimentarios.
En este sentido, se han desarrollado sistemas de monitoreo, como sensores de control de higiene, capaces de simular de forma efectiva las condiciones del entorno de procesado de alimentos y que representan una alternativa simple y eficiente a los métodos convencionales utilizados para el muestreo de superficies.
De forma adicional, se ha implantado un sistema de identificación y seguimiento mediante técnicas de análisis genético que permiten discriminar con precisión entre diferentes cepas de ‘listeria’ a lo largo de la cadena de producción de alimentos. De este modo se determina cuáles son las cepas predominantes y, por tanto, cuáles son las más resistentes a desinfectantes o a condiciones ambientales, aspectos clave para las industrias del sector.
Sector cárnico
La industria cárnica española es el ámbito de mayor importancia dentro de la industria de alimentación y bebidas. Castilla y León cuenta con más de 800 industrias, que suponen algo más del 26 % del total de las empresas agroalimentarias, con una producción del 12,5 % del volumen de carne en España. La calidad de los productos castellanos y leoneses se ve reflejada tanto en el número de figuras de reconocimiento (23) como en el incremento del volumen de exportaciones que se ha experimentado en los últimos años. Para los productores, garantizar la seguridad alimentaria es primordial, por lo que el control de microorganismos como puede ser la ‘Listeria monocytogenes’ constituye una prioridad.

















Normas de participación
Esta es la opinión de los lectores, no la de este medio.
Nos reservamos el derecho a eliminar los comentarios inapropiados.
La participación implica que ha leído y acepta las Normas de Participación y Política de Privacidad
Normas de Participación
Política de privacidad
Por seguridad guardamos tu IP
216.73.216.166